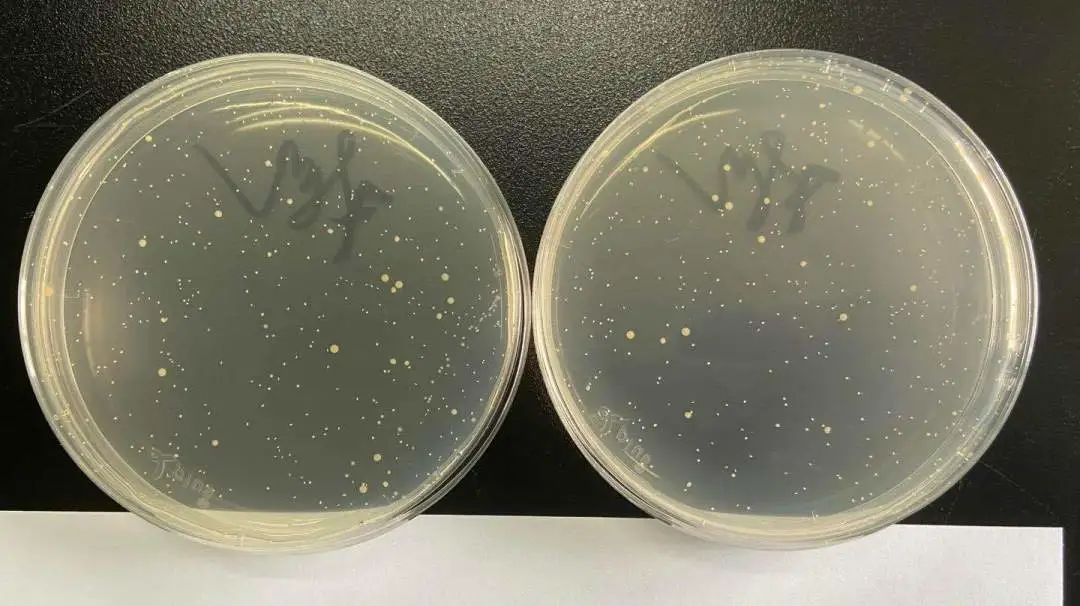

2020-07-06 14:07:08 来源:新浪财经-自媒体综合
比较试验 | 哪款洗手液、消毒湿巾更杀菌?我们测试了60件消毒品
来源:中国消费者协会
新冠肺炎疫情以来
大家越发重视起个人卫生防护
各类消毒产品一度脱销

抗(抑)菌洗手液
免洗洗手液、消毒湿巾
成为了人们
居家、上班、外出的必备用品
由于目前市场上这三类商品品牌众多,为帮助消费者购买到安全有效的消毒产品,上海市消保委对60件消毒类样品开展比较试验。(每类各20件)


产品宣称上,20件抗(抑)菌洗手液样品和19件免洗洗手液样品在产品包装上均有“抑菌、杀菌、抗菌”等字样,其中9件抗(抑)菌洗手液和5件免洗洗手液样品标明抑菌率。
20件消毒湿巾样品的产品包装上均有“抑菌、杀菌、抗菌”等字样,其中1件标明抑菌率。

比较试验的标准
比较试验依据《一次性使用卫生用品卫生标准》《消毒技术规范》等国家强制性标准以及《洗手液》《湿巾》国家推荐性标准,主要对样品的风险物质、消毒效果等进行了测试。
结果发现
① 全部样品风险物质均符合国家规定的限量要求。
② 4件样品实测乙醇含量与其包装明示不符。
③ 11件样品杀菌、抑菌效果好,且未有风险物质检出。
抗(抑)菌洗手液

淘宝心选
泡沫抗菌洗手液

滴露
滋润修护健康抑菌洗手液
免洗洗手液

展望可爱多
免洗抑菌洗手液

爱倍抑菌洗手液(免水型)

UNICAT
免洗洁净洗手液
消毒湿巾

湿博士
酒精湿巾

青蛙王子
卫生湿巾

憨贝洁
卫生湿巾

Cleomild酒精
杀菌湿巾

Sanjun50枚
杀菌卫生湿巾

好孩子婴儿卫生湿巾(海洋水润)

01
风险物质
甲醛是日化行业普遍使用的防腐剂,包括洗手液在内的许多洗涤产品都可能含有甲醛,二噁烷是洗手液在制作过程中的产物,荧光性物质被用作增白剂。如果这三种物质过量,会影响身体健康。
检测发现
全部样品均符合国家规定的限量要求,8件抗(抑)菌洗手液样品和19件免洗洗手液样品未检出甲醛、二噁烷,20件消毒湿巾均未检出可迁移性荧光增白剂,表现更好。
02
杀菌抑菌效果
比较试验针对日常生活中常见的五种致病菌代表菌种,在5秒、30秒、1分钟等7个时间点检测了60件样品对这五种致病菌的杀菌效果以及样品对大肠杆菌、金黄色葡萄球菌、白色念珠菌的抑菌率。
抑菌前

抑菌后
检测发现
杀菌性能上,60件样品均能杀灭规定的菌落数量,但杀菌速度差异明显,其中12件样品(9件消毒湿巾,3件抑菌洗手液)杀菌最快,能在5秒内迅速杀菌,15件样品和26件样品分别在1分钟和3分钟以内杀菌,7件免洗洗手液样品杀菌略慢,用时超过了3分钟。
抑菌性能上,60件样品均有抑菌作用,其中36件样品抑菌作用更强, 抑菌率在99%以上,13件样品抑菌作用较强,抑菌率在90-99%之间,11件样品抑菌作用略弱,抑菌率为50-90%之间。
三类样品杀菌起效时间

三类样品抑菌率


03
产品宣称
消费者在选购消毒产品时更看重杀菌抑菌功能, 目前很多产品会在包装上明示酒精含量,如“75%酒精”。



检测发现
4件样品实测乙醇含量与产品明示不符。
实测乙醇含量与明示不符的样品

消费提示
01/分清“卫消证字”和“妆”
普通洗手液的主要作用是去污清洁,而抗(抑)菌洗手液除了去污清洁,还具有一定的杀菌、抑菌作用。消费者在购买时要分清两种洗手液的类别。带有“卫消证字”的洗手液属于消毒产品范畴,而带有“妆”字的洗手液属于普通化妆品范畴。以洗手液为例,“消字”产品主要功能可含杀菌、抑菌等,“妆字”产品则以清洁为主。
02/选购注意
抗(抑)菌洗手液:选购时要注意观察产品有无分层或油水分离现象,如有则表明生产过程中乳化工艺不佳,洗涤效果较差。
免洗洗手液:一般含有60%以上的酒精,遇火即燃,储存时应远离高温、远离明火。在使用这类含酒精的免洗洗手液之后,不要立即靠近明火,例如点蚊香、抽烟、使用有明火的灶具等,避免发生意外。
消毒湿巾:建议消费者尽量选购有独立包装的湿巾。如选购非独立包装的湿巾,最好有密封贴、密封盖,抽取后及时贴好密封贴、盖好密封盖,能有效防止湿巾干燥和细菌滋生。
03/使用正确
抗(抑)菌洗手液:按“七步洗手法”对掌心、掌背等部位进行洗手,丰富的泡沫可以破坏携带大量病菌的油脂和污垢;在流动水下彻底冲净双手,整个过程为40-60秒。在擦干双手后建议涂抹护手霜,避免手部肌肤水分流失过快。另外,切忌为节省成本稀释洗手液,这样无论是杀菌能力还是清洁能力都会大打折扣。
免洗洗手液:取适量于掌心,双手互搓使之均匀涂布每个部位,充分作用至1-3分钟,即可有效杀灭手部病原微生物,但建议消费者仅在缺乏用水条件的时候使用,不要将其作为常规的手部清洁手段。另外,免洗洗手液中的杀菌成分会对皮肤、粘膜产生一定的刺激,尤其是婴幼儿及儿童,切勿将涂抹后的手指放入口中。
消毒湿巾:不建议用消毒湿巾擦拭脸部,尤其不要直接擦拭眼睛、中耳及粘膜处。如使用后出现红肿、发痒、疼痛等刺激反应时,应立即停止使用,以免造成更大伤害。使用消毒湿巾后,尽量避免用手直接接触食物,以免化学物质进入口腔内。
免责声明:本网站所有信息仅供参考,不做交易和服务的根据,如自行使用本网资料发生偏差,本站概不负责,亦不负任何法律责任。如有侵权行为,请第一时间联系我们修改或删除,多谢。
© 2018 今日中国财经 版权所有